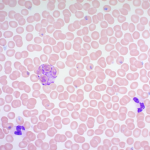

M.R.S乳酸菌培養基 | MRS agar Test of Lactic Acid Bacteria貨號NCM0035A

小型垂直電泳系統 | Major Science MV-10DSYS

TM-320快速消毒器 | 15公升桌上型高壓滅菌釜Autoclave貨號TM-320

角膜上皮細胞(Corneal epithelial cells) | ABMGOOD貨號T0737

>>GMS 染色試劑盒 | Modified Gomori Methenamine-Silver Nitrate Stain ScyTek貨號KAA-1 (125ML)

Rat Anti-Mouse Kappa-HRP抗體 | SBA貨號1170-05 規格1.0 mL

Spectrumlab透析夾 | SpectraPor® Tubing Closures/Universal Tubing Closures

BCA蛋白定量分析套組 | VisualProtein貨號BC03-500
Wright-Giemsa Stain Kit試劑盒 | Scytek貨號WGK-1 (500ml) WGK-2 (30ML)

Wright-Giemsa Stain Kit試劑盒 | 貨號k1438 (ABCAM, ab245888)
